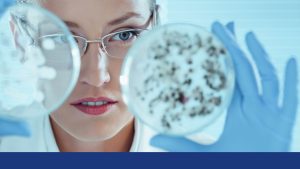

Tu plataforma confiable de educación médica continua
Mead Johnson y Saludiario te ofrecen un espacio especializado donde encontrarás contenidos actualizados, prácticos y relevantes para fortalecer tu práctica clínica diaria.
Consultorio

Apps médicas y privacidad: beneficios y riesgos que debes conocer
Apps médicas y privacidad: beneficios y riesgos que debes conocer En los últimos años, las aplicaciones médicas y de salud se han convertido en herramientas
Marketing

¿Cómo utilizar el marketing estacional en tu consulta médica?
Seguro que, alguna vez, has escuchado hablar del marketing estacional, un tipo que puede ayudarte a fidelizar a tus pacientes y conseguir nuevos. Si no

¿Sabes qué es Phygital y cómo puede mejorar la experiencia del paciente?
La pandemia ha propiciado la digitalización de los hábitos de compra y también ha puesto en valor la experiencia física. La combinación de dos mundos

3 consejos para mejorar la visibilidad online de tu consultorio
Tal y como adelantó Billl Gates en los años 80 (y que está vigente aún hoy en día) es que “lo que no está en
Estilo de vida

Lactancia materna y trabajo formal en México: cómo equilibrar derechos laborales y salud infantil
Lactancia materna y trabajo formal en México: cómo equilibrar derechos laborales y salud infantil La lactancia materna es uno de los pilares fundamentales para la

Calidad del sueño infantil en México: cómo influyen el entorno familiar y escolar
Calidad del sueño infantil en México: cómo influyen el entorno familiar y escolar El sueño infantil es un pilar fundamental para el desarrollo físico, cognitivo

Beneficios del mindfulness para reducir el estrés y mejorar la calidad de vida
El mindfulness, o atención plena, es una práctica que ayuda a reducir el estrés y mejorar la calidad de vida al fomentar una mayor conexión
Tecnología

Impacto de la inteligencia artificial en la detección temprana de enfermedades raras
Impacto de la inteligencia artificial en la detección temprana de enfermedades raras Las enfermedades raras afectan a millones de personas en todo el mundo, aunque
Inmunohistoquímica 3D: una revolución en el diagnóstico precoz
Inmunohistoquímica 3D: una revolución en el diagnóstico precoz La inmunohistoquímica (IHQ) ha sido, durante décadas, una técnica esencial en el diagnóstico anatomopatológico, permitiendo identificar proteínas

Uso de la inteligencia artificial en la práctica médica: beneficios y precauciones
La inteligencia artificial (IA) ha comenzado a transformar diversas áreas de la medicina, ofreciendo grandes avances en diagnóstico, tratamiento y gestión de pacientes. Los sistemas










